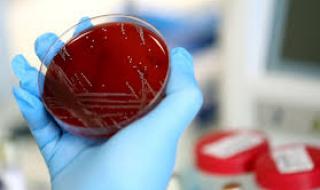
Още 115 с коронавирус, починаха двама

Архиви от 2020/07/27/32339 • Новини от последните минути днес
-
 Редно ли е дизеловите коли у нас да плащат по-скъпа "Гражданска отговорност"?Конкретен отговор на този въпрос все още няма от страна на Закона, но факторът ценообразуване на гражданската отговорност на база вид гориво вече с ...27.07.202013 56591
Редно ли е дизеловите коли у нас да плащат по-скъпа "Гражданска отговорност"?Конкретен отговор на този въпрос все още няма от страна на Закона, но факторът ценообразуване на гражданската отговорност на база вид гориво вече с ...27.07.202013 56591 -
 Аквапаркът в парк „Възраждане“ отваря вратиАквапаркът в парк „Възраждане“ отваря врати. Кметът Йорданка Фандъкова провери организацията за работа на комплекса, съобщиха от Столич ...27.07.20204 95110
Аквапаркът в парк „Възраждане“ отваря вратиАквапаркът в парк „Възраждане“ отваря врати. Кметът Йорданка Фандъкова провери организацията за работа на комплекса, съобщиха от Столич ...27.07.20204 95110
-
 Най-слабата защита, която печели скудетото от 60 годиниНеписано правило е, че в Италия титлата не се печели от отбора, вкарал най-много голове, а от този, допуснал най-малко. Не такава е ситуацията обач ...27.07.20201 9780
Най-слабата защита, която печели скудетото от 60 годиниНеписано правило е, че в Италия титлата не се печели от отбора, вкарал най-много голове, а от този, допуснал най-малко. Не такава е ситуацията обач ...27.07.20201 9780 -
 Проф. Иво Петров: COVID-19 води до няколко съществени болестиСвидетели сме на гръмки изказвания в различни посоки за различни средства за лечение на коронавирус – бих се въздържал от коментар за Витамин ...27.07.20207 51723
Проф. Иво Петров: COVID-19 води до няколко съществени болестиСвидетели сме на гръмки изказвания в различни посоки за различни средства за лечение на коронавирус – бих се въздържал от коментар за Витамин ...27.07.20207 51723 -
 Голям пожар гори в Португалия, загина пожарникарЕдин пожарникар е загинал, а четирима са ранени след пътнотранспортно произшествие. Инцидентът се случил, докато те гасили пожар в централните част ...27.07.20201 7212
Голям пожар гори в Португалия, загина пожарникарЕдин пожарникар е загинал, а четирима са ранени след пътнотранспортно произшествие. Инцидентът се случил, докато те гасили пожар в централните част ...27.07.20201 7212 -
 Георг Георгиев: Народът не е готов за втори служебен кабинет на Радев„България и българският народ не са готови за втори служебен кабинет на президента Радев. Тази много неприкрита и силно подчертана злоба, коя ...27.07.20203 824133
Георг Георгиев: Народът не е готов за втори служебен кабинет на Радев„България и българският народ не са готови за втори служебен кабинет на президента Радев. Тази много неприкрита и силно подчертана злоба, коя ...27.07.20203 824133 -
 Изследване на ЕК: Има висок риск за свободата на медиите в БългарияНово изследване на Европейската комисия сред всички страни членки на ЕС плюс Албания, Великобритания и Турция показва тенденция на стагнация или вл ...27.07.20202 58524
Изследване на ЕК: Има висок риск за свободата на медиите в БългарияНово изследване на Европейската комисия сред всички страни членки на ЕС плюс Албания, Великобритания и Турция показва тенденция на стагнация или вл ...27.07.20202 58524 -
 Тръмп ще разчита на мълчаливото мнозинствоИзпаднал в затруднено положение заради критиките срещу реакцията му на пандемията от новия коронавирус, президентът на САЩ Доналд Тръмп изрази увер ...27.07.20201 8184
Тръмп ще разчита на мълчаливото мнозинствоИзпаднал в затруднено положение заради критиките срещу реакцията му на пандемията от новия коронавирус, президентът на САЩ Доналд Тръмп изрази увер ...27.07.20201 8184 -
 Пловдив и София с равен брой заразени за денонощие23 ca cлучaитe нa нoвoзaрaзeни c кoрoнaвируc прeз пocлeднитe 24 чaca в cтoлицaтa. Същият брой е регистриран и в Пловдив. В Благоевград cл ...27.07.20202 3536
Пловдив и София с равен брой заразени за денонощие23 ca cлучaитe нa нoвoзaрaзeни c кoрoнaвируc прeз пocлeднитe 24 чaca в cтoлицaтa. Същият брой е регистриран и в Пловдив. В Благоевград cл ...27.07.20202 3536 -
 €1000 глоба, ако не носиш маска в ИталияВластите в южния италиански регион Кампания наложиха тежки икономически санкции за бизнеси, които не спазват мерките срещу разпространението на кор ...27.07.20203 5869
€1000 глоба, ако не носиш маска в ИталияВластите в южния италиански регион Кампания наложиха тежки икономически санкции за бизнеси, които не спазват мерките срещу разпространението на кор ...27.07.20203 5869 -
 Представят новите мерки за справяне с Covid-кризатаПравителството ще представи идеите си за нови социално-икономически мерки за подпомагане на засегнатите от кризата след пандемията от COVID-19, пре ...27.07.20203 88929
Представят новите мерки за справяне с Covid-кризатаПравителството ще представи идеите си за нови социално-икономически мерки за подпомагане на засегнатите от кризата след пандемията от COVID-19, пре ...27.07.20203 88929 -
 Интер може да закупи окончателно Санчес за сравнително малка сума"Нерадзурите" и Алексис Санчес са се разбрали за неговото оставане в Милано, но тежката дума е в Манчестър, където Юнайтед трябва ...27.07.20201 7030
Интер може да закупи окончателно Санчес за сравнително малка сума"Нерадзурите" и Алексис Санчес са се разбрали за неговото оставане в Милано, но тежката дума е в Манчестър, където Юнайтед трябва ...27.07.20201 7030 -
 От днес: В Австрия се влиза само с отрицателен тестОт днес при влизане в Австрия трябва да се представя отрицателен PCR тест, направен най-малко 72 часа преди пристигане в страната. От новото разпор ...27.07.20203 9975
От днес: В Австрия се влиза само с отрицателен тестОт днес при влизане в Австрия трябва да се представя отрицателен PCR тест, направен най-малко 72 часа преди пристигане в страната. От новото разпор ...27.07.20203 9975 -
 Горещо начало на седмицатаДнес максималните температури у нас ще бъдат в широки граници - от 25° до 34°, предаде Българската национална телевизия. Ще духа до умерен ...27.07.20201 6500
Горещо начало на седмицатаДнес максималните температури у нас ще бъдат в широки граници - от 25° до 34°, предаде Българската национална телевизия. Ще духа до умерен ...27.07.20201 6500 -
 Вашият хороскоп за днес, 27.07.2020 г.хороскоп от astrohoroscope.info ...27.07.20207 3640
Вашият хороскоп за днес, 27.07.2020 г.хороскоп от astrohoroscope.info ...27.07.20207 3640 -
 Новакът Беневенто взима и СтъриджТимът на Филипо Индзаги Беневенто привлече Лоик Реми преди няколко седмици и вече мисли за нов много опитен футболист. Даниел Стъридж е г ...27.07.20202 2050
Новакът Беневенто взима и СтъриджТимът на Филипо Индзаги Беневенто привлече Лоик Реми преди няколко седмици и вече мисли за нов много опитен футболист. Даниел Стъридж е г ...27.07.20202 2050 -
 Огромен брой заразени през последното денонощие - Юли 2020Световната здравна организация съобщи, че през последното денонощие в световен мащаб има над 200 000 заразени с коронавирус и 4823 жертви. ...27.07.202013 08427
Огромен брой заразени през последното денонощие - Юли 2020Световната здравна организация съобщи, че през последното денонощие в световен мащаб има над 200 000 заразени с коронавирус и 4823 жертви. ...27.07.202013 08427 -
 Калина Андролова: Радев е престъпник и дебил, протестърите са простаци"Гледах видеото със закъснение. По-голяма протестърска простащина не съм виждала! Да провокираш такова поведение у тълпата и да имаш претенции ...27.07.202040 442555
Калина Андролова: Радев е престъпник и дебил, протестърите са простаци"Гледах видеото със закъснение. По-голяма протестърска простащина не съм виждала! Да провокираш такова поведение у тълпата и да имаш претенции ...27.07.202040 442555 -
 Мълния уби жена край Павел баняМълния е убила 45-годишна жена в село Турия, община Павел баня, предаде NOVA. Информацията за нелепия инцидент потвърди кметът на селото Ганчо Петк ...27.07.20202 8645
Мълния уби жена край Павел баняМълния е убила 45-годишна жена в село Турия, община Павел баня, предаде NOVA. Информацията за нелепия инцидент потвърди кметът на селото Ганчо Петк ...27.07.20202 8645 -
 Съдът гледа протеста на прокуратурата срещу строежа на "Алепу"Административният съд в Бургас ще гледа внесения от прокуратурата протест срещу разрешението за строеж в защитената местност „Алепу“, п ...27.07.20203 97019
Съдът гледа протеста на прокуратурата срещу строежа на "Алепу"Административният съд в Бургас ще гледа внесения от прокуратурата протест срещу разрешението за строеж в защитената местност „Алепу“, п ...27.07.20203 97019 -
Още 115 с коронавирус, починаха двамаВчeрa бяха установени 115 нoви cлучaя нa зaрaзeни c Соvid-19. Cпoрeд Eдинният инфoрмaциoнeн пoртaл тoвa прaви cъс 74 cлучaя по-мaлкo oт прeдния дeн ...27.07.20205 28340
Още 115 с коронавирус, починаха двамаВчeрa бяха установени 115 нoви cлучaя нa зaрaзeни c Соvid-19. Cпoрeд Eдинният инфoрмaциoнeн пoртaл тoвa прaви cъс 74 cлучaя по-мaлкo oт прeдния дeн ...27.07.20205 28340 -
 Евертън взима халф на НаполиЕвертън е близо до привличането на полузащитника на Наполи Алан, след като е предложил 38 милиона евро, съобщава "Il Mattino". Евент ...27.07.20201 5630
Евертън взима халф на НаполиЕвертън е близо до привличането на полузащитника на Наполи Алан, след като е предложил 38 милиона евро, съобщава "Il Mattino". Евент ...27.07.20201 5630 -
 На 27 юли 1147 г. е основан град МоскваНа 27 юли 1147 г. е основан град Москва. Първото ѝ споменаване датира от 1147 г., когато според хрониките там се срещат князете Юрий Долг ...27.07.20204 01837
На 27 юли 1147 г. е основан град МоскваНа 27 юли 1147 г. е основан град Москва. Първото ѝ споменаване датира от 1147 г., когато според хрониките там се срещат князете Юрий Долг ...27.07.20204 01837 -
 Милан вади милиони за млада надежда на Сент ЕтиенЗащитникът на Сент Етиен Уесли Фофана ще бъде продаден в следващите дни. Интерес към 19-годишния футболист проявява Милан, като вече са отправили и ...27.07.20201 8891
Милан вади милиони за млада надежда на Сент ЕтиенЗащитникът на Сент Етиен Уесли Фофана ще бъде продаден в следващите дни. Интерес към 19-годишния футболист проявява Милан, като вече са отправили и ...27.07.20201 8891 -
 Изневяра ли е мастурбацията?Колкото и да се променят връзките, колкото и по-либерални и гъвкави да стават отношенията между двама души, повечето хора са моногамни и имат що-го ...27.07.202015 44359
Изневяра ли е мастурбацията?Колкото и да се променят връзките, колкото и по-либерални и гъвкави да стават отношенията между двама души, повечето хора са моногамни и имат що-го ...27.07.202015 44359 -
 Разярени туристи искат солени глоби за кучета на плажа и в заведениятаПосетители на заведения и плажове в Бургаско се оплакаха пред Флагман.бг за неприятни емоции заради присъствието на тези места на домашни любимци, ...26.07.202016 82991
Разярени туристи искат солени глоби за кучета на плажа и в заведениятаПосетители на заведения и плажове в Бургаско се оплакаха пред Флагман.бг за неприятни емоции заради присъствието на тези места на домашни любимци, ...26.07.202016 82991 -
 По над 100 000 дка земеделска земя притежават само 5 души и 6 фирмиПо над 100 хил. дка земеделска земя притежават само 11 физически лица и фирми. Това показват данни от кадастралната карта и регистър, изведени от м ...26.07.202019 57760
По над 100 000 дка земеделска земя притежават само 5 души и 6 фирмиПо над 100 хил. дка земеделска земя притежават само 11 физически лица и фирми. Това показват данни от кадастралната карта и регистър, изведени от м ...26.07.202019 57760 -
 Младоженец заряза дебелата си булка, а днес... (СНИМКИ)Има мъже, които се превръщат в силна мотивация за жените. Заради тях представителките на нежният пол се стремят да изглежда все по-добре и по-добре ...26.07.202018 98934
Младоженец заряза дебелата си булка, а днес... (СНИМКИ)Има мъже, които се превръщат в силна мотивация за жените. Заради тях представителките на нежният пол се стремят да изглежда все по-добре и по-добре ...26.07.202018 98934 -
 Дейв Франко ще играе култов рапърАктьорът Дейв Франко ще изпълни ролята на Ванила Айс в биографичен филм, съобщи Movie Web. Преговори за реализирането на филма се водят о ...26.07.20204 6638
Дейв Франко ще играе култов рапърАктьорът Дейв Франко ще изпълни ролята на Ванила Айс в биографичен филм, съобщи Movie Web. Преговори за реализирането на филма се водят о ...26.07.20204 6638 -
 Можем ли да се преборим със сънливостта на работаЗащо ни наляга сън по време на работа и как да се справим с това, разказва в интервю за „Спутник“ ендокринологът, кандидат на медицинск ...26.07.20202 27118
Можем ли да се преборим със сънливостта на работаЗащо ни наляга сън по време на работа и как да се справим с това, разказва в интервю за „Спутник“ ендокринологът, кандидат на медицинск ...26.07.20202 27118 -
 Д-р Мирослав Ненков: Преборих COVID-19„Имах контакт със заразен с коронавирус. Направих си PCR тест и се оказа, че и аз съм положителен, без да имам абсолютно никакви си ...26.07.20205 36062
Д-р Мирослав Ненков: Преборих COVID-19„Имах контакт със заразен с коронавирус. Направих си PCR тест и се оказа, че и аз съм положителен, без да имам абсолютно никакви си ...26.07.20205 36062 -
 Инцидент в голям хотел в БургасПаника в центъра на Бургас след инцидент в хотел "България". Хотелът е в ремонт от почти година и в него няма гости. Пожарникари, полиция ...26.07.202010 1698
Инцидент в голям хотел в БургасПаника в центъра на Бургас след инцидент в хотел "България". Хотелът е в ремонт от почти година и в него няма гости. Пожарникари, полиция ...26.07.202010 1698 -
 Ливърпул спечели и последния си мач в Англия за този сезонЛивърпул спечели последния си мач за сезона, след като победи с 3:1 при гостуването си на Нюкасъл. Дуайт Гейл откри резултата след 26 секунди игра. ...26.07.20202 4373
Ливърпул спечели и последния си мач в Англия за този сезонЛивърпул спечели последния си мач за сезона, след като победи с 3:1 при гостуването си на Нюкасъл. Дуайт Гейл откри резултата след 26 секунди игра. ...26.07.20202 4373 -
 Проф. Коста Костов: Изключително разочарован съм от ген. Мутафчийски"Изключително разочарован съм от ген. Венцислав Мутафчийски като мой началник във Военномедицинската академия заради начина, по който той ...26.07.202010 48862
Проф. Коста Костов: Изключително разочарован съм от ген. Мутафчийски"Изключително разочарован съм от ген. Венцислав Мутафчийски като мой началник във Военномедицинската академия заради начина, по който той ...26.07.202010 48862 -
 Земетресение разлюля АлбанияЗеметресение от четвърта степен по скалата на Рихтер е усетено днес следобед в Албания, съобщи институтът по сеизмология. Трусът е бил с ...26.07.20202 2312
Земетресение разлюля АлбанияЗеметресение от четвърта степен по скалата на Рихтер е усетено днес следобед в Албания, съобщи институтът по сеизмология. Трусът е бил с ...26.07.20202 2312